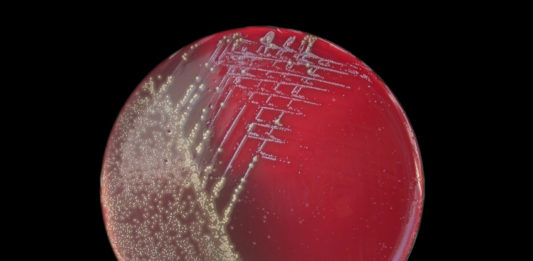
ANSA: vaccino pertosse causa contagio

GIURISPRUDENZA & Obiezione attiva in ambito vaccinale
da Comilva, una raccolta di ricorsi, decreti, ordinanze e sentenze riguardanti l'obiezione di coscienza e la libertà di scelta vaccinale.
DECRETO TRIB. MINORENNI BOLOGNA Settembre...
Vaccini: il Piano Globale
Vaccinazioni, Ordine Sanitario Mondiale
Vaccinazione per tutta la vita, vaccinazione in tutte le farmacie, le scuole, sui posti di lavoro o nei supermercati: una politica di...
Obbligo vaccino varicella in Italia, rispetta indicazioni OMS?
Ufficialmente con quali criteri è consigliato introdurre un obbligo vaccinale secondo l'OMS? Ce lo spiega l'articolo "La strana fretta di rendere obbligatoria la vaccinazione anti varicella"...
SIDS – Morte in culla e vaccini
La vaccinazione è uno dei primi interventi farmacologici a cui si sottopongono i bimbi a poche settimane dalla nascita. Fino a qualche tempo fa...
Vaccini PCV – Lo pneumococco non si fa vaccinare
Considerazioni sul vaccino antipneumococcico a cura del dott. Serravalle
Una conferma: la vaccinazione contro lo Streptococcus pneumoniae (pneumococco), ha portato a una significativa diminuzione dei casi...
Analisi vaccini: risposta ONB svela incompetenze del chimico Bella
Le analisi sui vaccini commissionate dall'associazione veneta Corvelva restano al centro del dibattito. Criticate da più fronti sembrano resistere all'attacco, forti del sostegno tecnico-scientifico...
Vaccini senza adiuvanti! Dal veterinario
Le campagne di vaccinazione veterinaria "su misura" sottolineano l’importanza di una
protezione vaccinale senza adiuvanti. Minore infiammazione, minori rischi.
"Ridurre l’infiammazione nel punto di iniezione è...
TV Svizzera – Inchiesta sul vaccino HPV Papillomavirus e Gardasil
Il papillomavirus (HPV) è considerato il principale responsabile del tumore femminile al collo dell'utero. Al momento dell'introduzione ufficialmente colpisce 1.800 italiane all'anno. Da questo...
Audizione senato 20.06.2017 Prevenzione vaccinale Ddl N. 2856
Pubblichiamo il documento che l’Associazione COMILVA Onlus ha presentato in Senato alla Commissione Igiene e Sanità il 20.06.2017, riguardante il Disegno di Legge N....
DEPLIANT VACCINI – Libera Scelta
Rendiamo disponibile il depliant sui vaccini realizzato dal gruppo di Libera Scelta per sensibilizzare nuovi genitori. Questa brochure sui vaccini è un invito a...
VITA CONTRO VITA: una questione morale
ll decreto legge Lorenzin, che impone l’obbligo di un mix di numerose vaccinazioni, con tutto il suo corredo di sanzioni e coercizioni, sta seguendo...
Vaccini obbligatori: scienza moderna e “scienza di Stato”
Da Altalex, l'inquietante e meticoloso ritratto dei meccanismi di censura imposti dalla nuova "politica medica dominante" in materia di vaccinazioni obbligatorie. "Pochi temi impegnano...
DEPLIANT VACCINI – Libera Scelta
Rendiamo disponibile il depliant sui vaccini realizzato dal gruppo di Libera Scelta per sensibilizzare nuovi genitori. Questa brochure sui vaccini è un invito a...
Morbillo: rimedi antichi e moderni
Un ascolto didattico per scoprire rimedi antichi e moderni per il morbillo, malanno contagioso tipico dell'infanzia, fino a poco tempo fa ritenuto importante per...
Convulsioni da vaccino MPR ed epilessia
Sapevi che le convulsioni da vaccino MPR (vaccino per morbillo-parotite-rosolia) hanno una frequenza 5 volte superiore rispetto ai casi di convulsione da morbillo? Mediamente nei...
ANSA: vaccino pertosse causa contagio
Il vaccino contro la pertosse non impedisce al soggetto vaccinato di diffondere l'infezione a soggetti non vaccinati e neonati, lo afferma un accreditato studio della...
12 vaccini obbligatori, sanzioni ed esclusione da asili
Su pressione del ministro della salute Beatrice Lorenzin, che di questo ha fatto una sua crociata personale, il Consiglio dei ministri ha dato l’ok...
Legge vaccini, sindaci biellesi: richiesti anticorpali e scuole aperte a tutti!
Sindaci biellesi in prima linea contro i rischi vaccinali e la discriminazione, consapevoli della necessità di accurate indagini e delle controindicazioni, portano in Regione...
Eventi e manifestazioni sui Vaccini 2017
Numerosi eventi per la libera scelta vaccinale, che caratterizzeranno i prossimi giorni:
02/06/2017
TRENTO: L’Associazione Vaccinare Informati Invita i cittadini ad un sit-in “silenzioso” per...
Stati Uniti, FDA: indagini sui virus cancerogeni nella produzione di vaccini
Un nuovo progetto di ricerca biologica prende il via grazie all'FDA (Food & Drugs Administration); l'ente governativo americano ha finalmente disposto analisi approfondite sui...
HPV: La grande battaglia si combatte ora!
Una delle domande più difficili che i genitori affrontano è: vacciniamo i nostri figli? Per alcuni la risposta è immediata, per altri no. Alcuni genitori...
Alluminio nei vaccini: storia e tossicità
Ecco il profilo tossicologico dell’alluminio, predisposto dall’Agenzia per le sostanze tossiche e registro delle malattie, o ATSDR.
Se si dovessero leggere le oltre 300 pagine...
10 SPORCHI VACCINI
Una dozzina di sporche ragioni ci costringono a questa implacabile trattazione sui vaccini. Il piano di vaccinazioni obbligatorie indifferenziate non è solo una roulette...
VACCINO MORBILLO INEFFICACE – Plotkin chiede nuovi studi
Vaccinazione morbillo inefficace contro i nuovi virus e difficoltà a stabilire il livello protettivo di anticorpi. Evidenze e critiche degne di riflessione, vista la fonte...
Nascita pre-termine e disturbi neuro-sviluppo: confronto vaccinati e non vaccinati
a cura della Dott.ssa Emma Pistelli -
Anthony Mawson, epidemiologo dell’Università Statale di Jackson, insieme ad altri autori ha recentemente pubblicato uno studio che mette in...
Emofilo influenza B (Hib): Istituto Superiore di Sanità si contraddice
a cura della redazione AsSIS
Il documento dell’Istituto Superiore di Sanità sull’impatto sulla popolazione delle 12 malattie oggetto degli obblighi vaccinali previsti dal decreto Lorenzin...
Vaccino pertosse inefficace, al via nuove ricerche sul batterio
Inefficacia e imperfezione del vaccino contro la pertosse sono note da anni. A causa della refrattarietà della pertosse all'attuale vaccino, l'Università di Southampton ha...
Vaccini, Giustizia al servizio della Scienza
La Procura di Roma ha chiesto l’archiviazione di un'importante indagine sulla sicurezza dei vaccini per "sanare la frattura tra scienza e società". La FNOMCeO è...
Vax tunnel, testimonianza di un papà
Cristiano, danneggiato da vaccinazione, si racconta. Ecco un'estratto dall'articolo pubblicato su Comilva. Questa è la sua storia.
"Sono nato nel freddo e nevoso gennaio del 1971,...
Vaccini ai militari: “Commissione Inchiesta Uranio impoverito” conferma tesi freevax
Pubblichiamo integralmente l'articolo di AsSIS - "L’approvazione del Decreto vaccini è coincisa con la pubblicazione della Relazione della Commissione d’inchiesta sull’uranio impoverito, che ha...